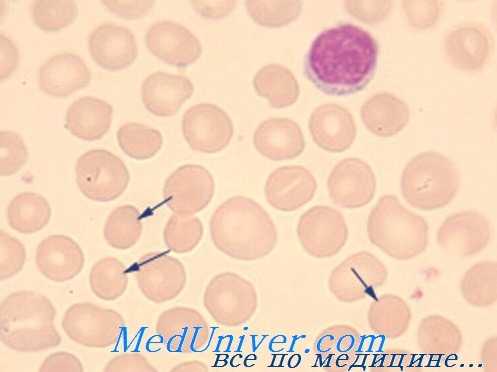
мазок крови при наследственном сфероцитозе

Наследственный овалоцитоз (врожденный эллиптоцитоз): клиника, диагностика, лечение
Добавил пользователь Евгений Кузнецов Обновлено: 28.01.2026
Что такое Наследственный сфероцитоз (болезнь Минковского-Шоффара) -
Наследственный сфероцитоз (болезнь Минковского-Шоффара) - гемолитическая анемия вследствие дефекта клеточной мембраны эритроцитов, проницаемость мембраны для ионов натрия становится избыточной, в связи с чем эритроциты приобретают шарообразную форму, становятся ломкими и легко подвергаются спонтанному гемолизу.
Наследственный сфероцитоз является широко распространенным заболеванием (2-3 случая на 10000 населения) и встречается у лиц большинства этнических групп, однако чаще болеют жители северной части Европы.
Что провоцирует / Причины Наследственного сфероцитоза (болезни Минковского-Шоффара):
Наследственный сфероцитоз передается по аутосомно-доминантному типу. Как правило, у одного из родителей выявляют признаки гемолитической анемии. Возможны спорадические случаи заболевания (в 25%), представляющие собой новые мутации.
Патогенез (что происходит?) во время Наследственного сфероцитоза (болезни Минковского-Шоффара):
В патогенезе наследственного сфероцитоза бесспорны 2 положения: наличие генетически детерминированной аномалии белков, или спектринов, мембраны эритроцитов и элиминирующая роль селезенки в отношении сфероидальноизмененных клеток. У всех больных с наследственным сфероцитозом отмечен дефицит спектринов в эритроцитарной мембране (до 1/3 нормы), а у некоторых - нарушение их функциональных свойств, причем установлено, что степень дефицита спектрина может коррелировать с тяжестью заболевания.
Наследственный дефект структуры мембраны эритроцитов приводит к повышенной проницаемости ее для ионов натрия и накоплению воды, что в свою очередь ведет к чрезмерной метаболической нагрузке на клетку, потере поверхностных субстанций и формированию сфероцита. Формирующиеся сфероциты при движении через селезенку начинают испытывать механическое затруднение, задерживаясь в красной пульпе и подвергаясь всем видам неблагоприятных воздействий (гемоконцентрация, изменение рН, активная фагоцитарная система), т.е. селезенка активно наносит сфероцитам повреждения, вызывая еще большую фрагментацию мембраны и сферуляцию. Это подтверждается при электронно-микроскопических исследованиях, позволивших обнаружить ультраструктурные изменения в эритроцитах (утолщение клеточной мембраны с ее разрывами и образованием вакуолей). Через 2-3 пассажа через селезенку сфероцит подвергается лизису и фагоцитозу. Селезенка является местом гибели эритроцитов; продолжительность жизни которых сокращается до 2 недель.
Хотя дефекты эритроцитов при наследственном сфероцитозе обусловлены генетически, в организме возникают условия при которых углубляются эти дефекты и реализуется гемолитический криз. Кризы могут провоцироваться инфекциями, некоторыми химическими веществами, психическими травмами.
Симптомы Наследственного сфероцитоза (болезни Минковского-Шоффара):
Наследственный сфероцитоз может проявляться с неонатального периода, однако более выраженные симптомы обнаруживают к концу дошкольного и в начале школьного возраста. Раннее проявление заболевания предопределяет более тяжелое течение. Чаще болеют мальчики.
Наследственный сфероцитоз - гемолитическая анемия с преимущественно внутриклеточным типом гемолиза, это обусловливает и клинические проявления болезни - желтуху, увеличение селезенки, большую или меньшую степень анемии, склонность к образованию камней в желчном пузыре.
Жалобы, клинико-лабораторная симптоматика во многом определяются периодом заболевания. Вне гемолитического криза жалобы могут отсутствовать. При развитии гемолитического криза отмечаются жалобы на повышенную утомляемость, вялость, головную боль, головокружение, бледность, желтуху, снижение аппетита, боли в животе, возможны повышение температуры до высоких цифр, тошнота, рвота, учащение стула, грозный симптом - появление судорог.
Симптоматика криза во многом определяется анемией и зависит от степени гемолиза.
При объективном обследовании кожа и видимые слизистые бледные или лимонно-желтые. У детей с ранними проявлениями наследственного сфероцитоза возможны деформации скелета, особенно черепа (башенный, квадратный череп, изменяется расположение зубов и т.д.); нередки генетические стигмы. У больных обнаруживаются разной степени выраженности изменения со стороны сердечно-сосудистой системы, обусловленные анемией. Характерен гепатолиенальный синдром с преимущественным увеличением селезенки. Селезенка плотная, гладкая, нередко болезненная, что, по-видимому, объясняется напряжением капсулы вследствие кровенаполнения или периспленитом. Окраска экскрементов в момент криза интенсивная. Следует отметить возможные колебания в размерах селезенки: значительное увеличение при гемолитических кризах и уменьшение в период относительного благополучия.
В зависимости от тяжести наследственного сфероцитоза клинические симптомы могут быть выражены незначительно. Иногда желтуха может быть единственным симптомом, по поводу которой больной обращается к врачу. Именно к этим лицам относится известное выражение Шоффара: "Они более желтушны, чем больны." Наряду с типичными классическими признаками заболевания встречаются формы наследственного сфероцитоза, когда гемолитическая анемия может быть настолько хорошо компенсирована, что пациент узнает о заболевании лишь при проведении соответствующего обследования.
Наряду с наиболее типичными гемолитическими кризами при тяжелом наследственном сфероцитозе возможны арегенераторные кризы с симптомами гипоплазии преимущественно красного ростка костного мозга. Такие кризы могут развиваться остро с довольно яркими симптомами анемии-гипоксии и наблюдаются обычно у детей после 3 лет жизни. Арегенераторные кризы кратковременны (1-2 недели) и носят обратимый характер в отличие от истинной аплазии.
Наследственный сфероцитоз осложняется образованием пигментных камней в желчном пузыре и желчных протоках, после 10 лет камни желчного пузыря встречаются у половины больных, не подвергнутых спленэктомии.
Диагностика Наследственного сфероцитоза (болезни Минковского-Шоффара):
Диагноз наследственный сфероцитоз ставится на основании генеалогического анамнеза, клинических данных, описанных выше и лабораторных исследований. Гемолитическую природу анемии подтверждают нормохромная нормоцитарная анемия с ретикулоцитозом, непрямая гипербилирубиннемия, степень выраженности которых зависит от тяжести гемолиза. Окончательный диагноз основывается на морфологических особенностях эритроцитов и характерном признаке наследственного сфероцитоза - изменении осмотической резистентности эритроцитов.
Течение наследственного сфероцитоза волнообразное. Вслед за развитием криза улучшаются клинико - лабораторные показатели и наступает ремиссия, которая может длиться от нескольких недель до нескольких лет.
Дифференциальный диагноз. Наследственный сфероцитоз следует дифференцировать от других врожденных гемолитических анемий. Данные семейного анамнеза, исследование мазков крови и осмотической резистентности эритроцитов отличаются наибольшей диагностической ценностью.
Из других заболеваний наследственный сфероцитоз прежде всего дифференцируют с гемолитической болезнью новорожденных, в более старшем возрасте - с вирусным гепатитом, аутоиммунной гемолитической анемией.
Лечение Наследственного сфероцитоза (болезни Минковского-Шоффара):
Радикальным методом лечения наследственного сфероцитоза является спленэктомия, которая обеспечивает практическое выздоровление, несмотря на сохранность сфероцитов и снижение осмотической резистентности (степень их выраженности уменьшается). Оптимальный возраст для проведения операции 5-6 лет. Однако возраст не может рассматриваться как противопоказание к хирургическому лечению. Тяжелые гемолитические кризы, их непрерывное течение, арегенераторные кризы - показания для проведения спленэктомии даже у детей раннего возраста. Существует повышенная склонность к инфекционным заболеваниям в течение 1 года после операции. В связи с этим в ряде стран принято ежемесячное введение в течение одного года после спленэктомии бициллина - 5 или перед плановой спленэктомией проводят иммунизацию пневмококковой поливакциной.
Прогноз при наследственном сфероцитозе благоприятный. Однако, в тяжелых случаях гемолитического криза при несвоевременном лечении является серьезным (возможен летальный исход).
Так как наследственный сфероцитоз наследуется по аутосомно-доминантному типу с довольно высокой пенетрантностью гена, необходимо учитывать, что степень риска рождения больного ребенка (любого пола) при наличии наследственного сфероцитоза у одного из родителей составляет 50%. Дети, больные наследственным сфероцитозом, находятся на постоянном диспансерном учете.
Диета. Введение в рацион повышенного количества фолиевой кислоты (более 200 мкг/сут). Рекомендуемые продукты: хлебобулочные изделия из муки грубого помола, гречневая и овсяная крупы, пшено, соя, фасоль, измельченные сырые овощи (цветная капуста, зелёный лук, морковь), грибы, говяжья печень, творог, сыр.
Профилактика Наследственного сфероцитоза (болезни Минковского-Шоффара):
Наследственный сфероцитоз предупредить невозможно. Однако люди, больные наследственным сфероцитозом, могут обратиться к консультанту-генетику с тем, чтобы обсудить возможности определения дефектного гена, вызываю¬щего заболевание их детей.
Профилактика наследственного сфероцитоза сводится к лечебным мероприятиям во время кризов.
К каким докторам следует обращаться если у Вас Наследственный сфероцитоз (болезнь Минковского-Шоффара):
Вас что-то беспокоит? Вы хотите узнать более детальную информацию о Наследственного сфероцитоза (болезни Минковского-Шоффара), ее причинах, симптомах, методах лечения и профилактики, ходе течения болезни и соблюдении диеты после нее? Или же Вам необходим осмотр? Вы можете записаться на прием к доктору .
Наследственный овалоцитоз (врожденный эллиптоцитоз): клиника, диагностика, лечение
Наследственный овалоцитоз (синоним — врожденный эллиптоцитоз) врожденная болезнь, характеризующаяся наличием высокого процента овальных эритроцитов в периферической крови, с нередко сопутствующей анемией гемолитического вида.
История изучения наследственного овалоцитоза. Впервые болезнь описал Dresbach в 1904 г. на 22-летнем заболевшем мулатре. В 1914 г. Bishop описал ее семейный характер a Wyandtn сотр. (1941) ссылаются на 246 описанных в литературе случаев в 64 семьях. С тех пор в литературе публикуются довольно частые случай разнообразных клинических форм.
Этиология и патогенез наследственного овалоцитоза. Болезнь носит наследственный характер, передается как доминантная черта и в одинаковой мере поражает лиц обоего пола. Поскольку речь идет о доминантном гене, в принципе проникновение болезни должно быть 100%, даже и в тех случаях, когда один из родителей здоров.
Тем не менее бывает и так, что, на вид, данное лицо здорово, хотя один из родителей (передающий отягчение) и ряд других его детей больны. Это подсказывает мысль о возможно неполном проникновении, а в связи с этим и селективной выраженности доминантного гена.
Описано также наличие линкажа эллиптоцитоза с резусгенотипом, поскольку оба расположены по соседству в том же хромосоме.
Морфофункциональная почва аномалии не вскрыта, видимо она находится в оболочке эритроцита (Piguet и сотр.).

Клинические признаки наследственного овалоцитоза
В 1950 г. Гейльмейер описал следующие три клинических вида эллиптоцитоза — без гемолиза, с компенсированным гемолизом и декомпенсированным гемолизом.
В большинстве случаев (80—90%) эллиптоцитоз протекает как латентное заболевание, без клинических признаков, обнаруживается случайно при семейных анкетах или прочете гемограммы.
В отдельных случаях эллиптоцитоза отмечается сокращение продолжительности жизни эритроцитов и компенсаторная реакция костного мозга, которая отражается в повышении целлюлярности, наличии завышенного числа нормально созревающих эритробластов, высоком показателе ретикулоцитов в периферической крови и мало повышенном косвенном билирубине.
Отсутствуют анемия и желтушная окраска. Однако описаны виды эллиптоцитоза с полиглобулией.
В иных случаях (5—10%, в зависимости от автора) отмечается одновременное наличие скрытой анемии и приступов преходящей деглобулизации, подобно обнаруживаемых при наследственном сфероцитозе. Описаны и случаи роствовесовых и соматопсихических сдвигов, подобно наблюдаемых при тяжелых формах внутриэритроцитной гемолитической анемии.
Выраженно эллиптическая форма этих эритроцитов нарушает внутриселезеночное кровообращение; были и явные случаи селезеночной секвестрации, при которых спленэктомия сокращала гемолиз.
Лабораторные признаки наследственного овалоцитоза
Наличие невысокого процента овалоцитов (1—15%), между продольным и поперечным диаметром которых разница невелика (8u/6u) можно рассматривать как физиологический факт. При наследственном овалоцитозе число эллиптических эритроцитов завышено, при этом разница между диаметрами может оказаться существенной (бактериоциты).
В случаях умеренной формы заболевания их численность не составляет более 20—30%, в то время как при тяжелых — превышает 90%. Костномозговые предшественники эритроцитов имеют нормальный вид, овалоцитоз развивается лишь после стадии ретикулоцита.
Терапия наследственного овалоцитоза
Заболевание, в котором отсутствуют клинические признаки, не требует лечения и его следует рассматривать в основном как гематологическая странность.
В гемолитических и развивающих анемию случаях лечение одинаково с наследственным сфероцитозом - в основном спленэктомия.
Редактор: Искандер Милевски. Дата обновления публикации: 18.3.2021
Информация на сайте подлежит консультации лечащим врачом и не заменяет очной консультации с ним.
См. подробнее в пользовательском соглашении.
Лечение наследственного сфероцитоза - спленэктомия
Профилактическое лечение наследственного сфероцитоза (микросфероцитоза). Генетический совет. При таком заболевании, равно как и при многих других наследственных болезнях, указания врача составляют социальную потребность, естественно в условиях правильного освоения и применения метода. Следует предполагать, что многие супружеские пары добровольно согласились бы устранить риск передачи подобного отягчения их возможному потомству.
Соблюдение супругами указаний врача имело бы больше шансов если у данных родителей уже имеется один страдающий ребенок. Следует считать грубой ошибкой врача непредупреждение родителей об отрицательных последствиях рождения аномальных детей.
Терапевтическое лечение наследственного сфероцитоза (микросфероцитоза). Спленэктомия. Это единственный эффективный метод, приводящий к улучшению здоровья, причем в отдельных случаях даже к клинической нормализации. Гейльмейер и Буш сообщили о случае, в котором соответствующий больной ежегодно праздновал день спленэктомии как дату повторного рождения, поскольку лишь после хирургического вмешательства он начал по существу жить.
В большинстве случаев полижительные результаты спленэктомии наблюдаются уже в первые дни после операции. Даже когда эффекты вмешательства более скромны, все же удаление селезенки следует считать целесообразным методом. За исключением отдельных случаев со слабо выраженной симптоматологией, спленэктомия показана для всех страдающих наследственным сфероцитозом.
С давних времен наблюдения выявили понижение анемии и желтухи после проведения спленэктомии. Недавно проведенные исследования на основе маркирования эритроцитов радиоактивными изотопами, доказали, во всех случаях, удлинение срока жизни эритроцитов, хотя внутрительцовый дефект не исправляется удалением селезенки.

Спленэктомия при наследственном сфероцитозе
По этой причине лабораторные исследования, отражающие недостаток эритроцита (сфероцитоз, понижение осмотической устойчивости и пр.) не изменяются после сленэктомии, в то время как клинические и биологические, выявляющие высокую степень разрушения эритроцитов, указывают на существенное улучшение (общее состояние здоровья, психосоматическое развитие, содержание гемоглобина в крови, билирубинемия, выделение уробилиновых телец и пр.).
Однако после удаления селезенки отмечается рост сидероцитов (примерно на 10%), пойкилоцитов, телец Jolly, лейкоцитов, тромбоцитов и пр. в результате упразднения физиологических функций этого органа.
Спленэктомию показано проводить детям старше 4—5-летнего возраста, за ислючением тех тяжелых случаев, при которых анемия и желтуха ставят под угрозу собственно жизнь. Спленэктомия проводимая до 3-летнего возраста, и особенно на первых 6 месяцах жизни, предрасполагает к инфекции с тяжелым течением. Спленэктомию не проводить в период «деглобулизации», поскольку это мало влияет на течение приступа.
Риск хиругрического вмешательства невелик; у опытного хирурга послеоперационная смертность не достигает 1%. При этом опасность операции прямо пропорциональна объему селезенки. Так, крупная селезенка нередко создает технические трудности операции в связи с воспалительными околоселезеночными процессами, ведущими к образованию спаек с соседними органами. Часть случаев летального исхода относится за счет реактивного тромбоза, способствующему развитию тромбоза в портальной или полой вены.
Хирургическому вмешательству должно предшествовать рентгенологическое обследование желчных путей. В процессе спленэктомии для хирурга важно выведать и удалить иногда небольшие но не редкие дополнительные селезенки, за счет которых относятся некоторые неудачи спленэктомии (Piguet и сотр.).
Прочие терапевтическое способы лечения наследственного сфероцитоза (микросфероцитоза). Помимо спленэктомии не распо лагаем иными основными терапевтическими возможностями. В периоды приступов «деглобулизации», когда резко развивающаяся анемия ставит под угрозу жизнь больного, переливание крови обязательно. Быстрое применение привело к существенному сокращению показателя смертных случаев, отмечавшихся до внедрения последнего в терапевтическую практику всех диспансеров.
Тем не менее в связи с опасностью передачи эпидемического гепатита больным с повторными переливаниями, целесообразно исползьовать трансфузию лишь в случае понижения гемоглобина до менее 7—8%.
Назначение гормонов (кортикоидных, андрогенных), железа, витаминов, микроэлементов и пр. в принципе бессмысленно.
Лабораторная диагностика наследственного сфероцитоза - анализы при микросфероцитозе
Лабораторные признаки наследственного сфероцитоза касаются гематопоэза и гемолиза. Гематопоэз при микросфероцитозе в периферической крови:
а) Ряд красной крови. Число красных кровяных клеток сокращается не на много, их показатель колеблется от 3 000 000 до 4 000 000, при этом гемоглобин уменьшается соответственно (анемия нормохромного вида). Тем не менее после явления «деглобулизации » число эритроцитов значительно понижается.
Патогномоничным для этого заболевания считается наличие микросфероцитов на мазке крови. Они характеризуются уменьшением среднего диаметра эритроцитов и ростом их средней толщины, в связи с чем эритроциты кажутся уменьшенными, сильнее окрашенными и без центральной светлой зоны. Объем красных кровяных клеток может укладываться в норму, но их площадь существенно уменьшена.
Процент микросфероцитов колеблется от одного больного и другому, наиболее часто их пропорция составляет 20—25%, в отдельных случаях показатель равняется 50%, а в виде исключения достигает 90%; иногда отношение весьма занижено (примерно 5%).
Ретикулоцитоз. Его наличие почти постоянное, причем в принципе показатель составляет 3—25%. Рост до более 50% отмечается после приступа «деглобулизации». На мазке наблюдаются и другие признаки регенерации эритроцитов, такие как полихроматофилия, ядерные внутриэритроцитные остатки (тельца Howell-Jolly) и эритробласты. Вообще кривая Price-Jones имеет два пика — один из них расположен по левую сторону среднего диаметра эритроцита (микросфероцитная популяция), в то время как другой — по правую сторону (наличие ретикулоцитов).
б) Ряд лейкотромбоцитов мало изменен. Во время приступа «деглобулизации» наряду с провалом ретикулоцитоза может развиться гранулоцитопения, а затем значительно растет показатель численности нейтрофильных гранулоцитов с отклонением влево ряда (до миелоцита). Это свидетельствует о том, что высокая активность костного мозга на межприступной фазе охватывает и систему лейкоцитов.
Кроветворение в костном мозге при наследственном сфероцитозе
а) Миелограмма выявляет обильный костный мозг. Отношение гранулоциты/эритробласты указывает на гиперплазию последних. Кривая созревания в норме, по всем рядам. Эритропоэз нормобластический, образование микросфероцитов осуществляется лишь в периферической крови. Сделанная в начале приступа «деглобулизации» пункция выявляет резкое падение показателя численности предшественников красных кровяных клеток, создавая картину острого разрушения эритробластов.
в) Биоптическое исследование костей выявляет гиперактивный костный мозг — гематопоэтическая ткань распространяется на жирные вакуоли, количество которых сокращается, вплоть до полного исчезновения в отдельных зонах. Гиперплазия красного костного мозга распространяется и на значительную часть отростков трубчатых костей и собственно строение костей находится под воздействием распространяющейся костномозговой гипертрофии.
Расплавление крови результат нарушенной устойчивости красных кровяных клеток.
а) Осмотическая устойчивость. Неустойчивость эритроцитов к гипотонным растворам относится за счет их сферической формы, поскольку, при нормальном объеме, площадь существенно уменьшается. Обследование невооруженным глазом дает возможность определить, что нормальный гемолиз начинается при концентрации NaCl в пропорции 0,45% и считается полным при 0,35%; в условиях фотометрического определения начало гемолиза отмечается при 0,52% и заврешается при 0,3%.
Сфероцитоз отличается резко заниженной осмотической устойчивостью, при этом начало приближается к значениям физиологического раствора (0,8%) и завершается примерно к 0,4%. Поскольку классическое исследование зачастую оказывается недостаточно чувствительным для постановки диагноза, предложено определять устойчивость в условиях инкубации; способ заключается в определении осмотической устойчивости после суточной инкубации при 37°С, предельные значения располагаются от 0,75 до 0,15% NaCl. Тем не менее даже этим тестом не удалось выявить всех клинических здоровых носителей этого отягчения (Heilmever L., Busch D.).
б) Механическая устойчивость эритроцитов также занижена при наследственном сфероцитозе, однако не достигая отмечаемого уровня при гомозиготной талассемии.
Как осмотическая, так и механическая устойчивость не устраняются применением спленэктомии.
в) Тест аутогемолиза по Selwyn и Dacie. Эритроциты, стерильно отобранные и сохраненные в собственной плазме в термостате при 37°С в течение 48 ч. подвергаются более интенсивному процессу расплавления, чем нормальные красные кровяные клетки. Этот процесс расплавления корригируется добавлением глюкозы в инкубационную среду.
Последствия высокого гемолиза при наследственном сфероцитозе и порядок их чередования следующие:
а) Билирубинемия в любом случае высокая с преобладанием несопряженной фракции (в связи с чем реакция косвенная). Уровень достигает 3—4 мг/100 мл, в случае роста до более 5 мг/100 мл следует заподозрить одновременное поражение печени. Поскольку способность гликуронирования печени примерно в 10 раз больше физиологического сопряжения, росту билирубина в сыворотке сопутствует пропорционально повышенное желчное выделение. Рост сопряженного билирубина невелик, составляя примерно 15% общего билирубина. В период приступа «деглобулизации» (аплазии) показатель билирубина понижается.
Гемоглобинемия отсутствует или незначительно повышается; гаптоглобин сыворотки — невысок.
Признаком высокого показателя расплавления крови является и рост активности сыворотчной лактикодегидрогеназы. Сидеремия колеблется, однако в большинстве случаев количество железа в сыворотке увеличивается.
б) Тесты с изотопами — все чаще применяемые в клинике — выявляют сокращенную продолжительность жизни эритроцитов, составляя в среднем 20—30 дней и почти ислючительную секвестрацию в селезенке.
в) Уробилиноген. Косвенный билирубин имеет крупную молекулу (билирубин-альбумин) и по этой причине не выделяется с мочой. Вот почему моча не окрашивается в цвет «черного пива», как при печеночной желтухе, а приобретает коричнево-красный оттенок, как при ахолурической желтухе (с высоким показателем уробилиногена). При этом реакция желчных солей в моче отрицательная.
г) Испражнения резко окрашены, из-за большого количества выделяемого стеркобилиногена.
Наследственный эллиптоцитоз
Наследственный эллиптоцитоз, или овалоклеточная анемия, - наследственно обусловленная форма гемолитической анемии. Овальные эритроциты (эллиптоциты) наблюдаются и у здоровых людей, их количество может достигать 10 %. При наследственном эллиптоцитозе овальных эритроцитов значительно больше, в пределах 25-75 %.
Наследственный эллиптоцитоз обычно делят на три большие группы:
1. наследственный эллиптоцитоз с дискоидальными эллиптоцитами;
2. сфероцитарный или овалоцитарный наследственный эллиптоцитоз;
3. наследственный эллиптоцитоз с наличием стоматоцитов (называемый также меланезийским или южно-азиатским овалоцитозом), при котором эритроциты имеют округлую форму с неокрашенным участком в центре эритроцита, ограниченным двумя изогнутыми линиями, соединенными по бокам.
Что провоцирует / Причины Наследственного эллиптоцитоза:
Наследственный эллиптоцитоз наследуется аутосомно-доминантным путем; его частота варьирует от 0,02 до 0,05 % в популяции среди различных этносов мира. При электрофорезе у части больных отсутствует белок полосы 4,1. Эритроциты имеют форму эллипса, их деформируемость снижена, в связи с чем они быстро разрушаются в селезенке.
Патогенез (что происходит?) во время Наследственного эллиптоцитоза:
Дефицит гликофорина С может появляться вследствие отдельных молекулярных дефектов. У лиц гомозиготных по гликофорину С, наблюдается эллиптоцитоз без анемии.
Эритроцитарные предшественники при наследственном эллиптоцитозе имеют округлую форму: эритроциты приобретают эллиптоидную форму только при выходе из КМ. Предполагается, что эритроциты при наследственном эллиптоцитозе постоянно стабилизированы на их патологическую форму реорганизацией скелетона при контакте клеток с новыми белками (сыворотка крови).
Симптомы Наследственного эллиптоцитоза:
Выделяют бессимптомную форму эллиптоцитоза, эллиптоцитарную гемолитическую анемию как нозологическую форму и симптоматический эллиптоцитоз при других заболеваниях.
Течение наследственного эллиптоцитоза в подавляющем большинстве случаев (95%) бессимптомное. Однако следует помнить, что наличие эллиптоцитоза не всегда свидетельствует о его наследственном характере, поскольку у здорового человека около 15% эритроцитов также имеют эллипсовидную форму. Клинически в манифестных случаях наблюдаются желтушность кожи и склер, спленомегалия, нередко диагностируются холелитиаз, изменения костного скелета.
Диагностика Наследственного эллиптоцитоза:
Лабораторная диагностика наследственного эллиптоцитоза основана на выявлении эллиптоцитов, которые иногда имеют форму палочки. Если в норме соотношение взаимно перпендикулярных диаметров эритроцита приближается к 1, то при эллиптоцитозе оно снижается до 0,78. Могут встречаться мишеневидные эритроциты, а эллиптоциты могут иметь различные размеры и нормохромную окраску.
Цветовой показатель не отклоняется от нормы, уровень гемоглобина даже у гомозиготов не бывает низким, варьируя от 90 до 120 г/л. Количество ретикулоцитов увеличивается умеренно - до 4 %; осмотическая резистентность эритроцитов чаще понижена, но может быть и нормальной; в последнем случае проводят пробы с инкубацией эритроцитов и пробу на аутолиз, которые обнаруживают снижение осмотической резистентности эритроцитов.
Лечение Наследственного эллиптоцитоза:
Лечебные мероприятия при эллиптоцитарной гемолитической анемии аналогичны используемым при наследственном микросфероцитозе.
Прогноз благоприятный у больных, перенесших спленэктомию, у остальных возможно развитие тяжелых гемолитических кризов, желчнокаменной болезни, тромбозов.
Профилактика Наследственного эллиптоцитоза:
К каким докторам следует обращаться если у Вас Наследственный эллиптоцитоз:
Вас что-то беспокоит? Вы хотите узнать более детальную информацию о Наследственного эллиптоцитоза, ее причинах, симптомах, методах лечения и профилактики, ходе течения болезни и соблюдении диеты после нее? Или же Вам необходим осмотр? Вы можете записаться на прием к доктору .
Читайте также:
